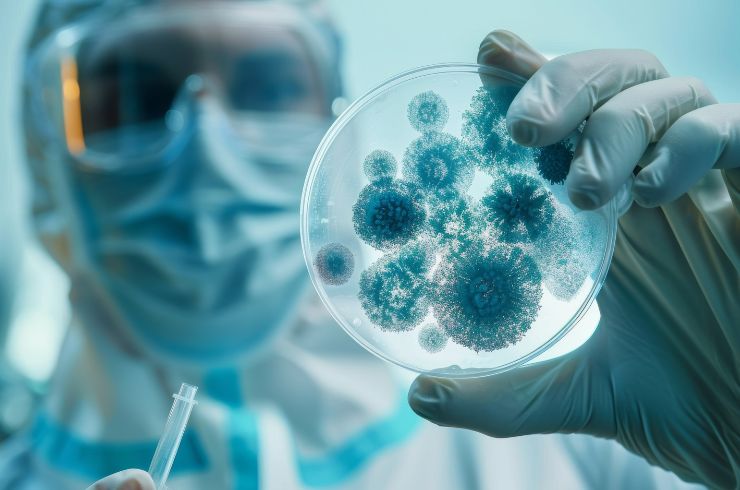

Delivering accurate reports with care and precision to every patient.


At Abhi Diagnostic Centre, Parasala, we take pride in being a trusted franchise partner of Aster Labs, one of the most respected and rapidly growing names in healthcare diagnostics across South India. Backed by the strong legacy of Aster DM Healthcare, a global healthcare conglomerate founded by the visionary Dr. Azad Moopen, we bring advanced diagnostic solutions, world-class technology, and uncompromising accuracy to the people of Parasala in Trivandrum district, Kerala.
Accurate results delivered with reliability, ensuring confidence in every test.
Cutting-edge equipment ensures precise diagnostics for improved patient outcomes.
Qualified professionals ensure accurate interpretations with compassionate patient care.
Wide specialties under one roof, meeting diverse diagnostic healthcare needs.
Strong network of Aster Labs assures global quality and trust.
High-quality diagnostic services offered at reasonable, transparent pricing.
| Package Name | Package Code | Test Name | No. of Tests | MRP | Offer Price for Customer |
|---|---|---|---|---|---|
| Onam Wellness Care | O0060 | GLUCOSE, FASTING (F) | 55 | 4045 | 999 |
| Hemogram (CBC + ESR) | |||||
| TSH | |||||
| Lipid Profile | |||||
| Liver Function Test | |||||
| HbA1c | |||||
| Kidney Function Test | |||||
| HsCRP | |||||
| Vitamin D25 Hydroxy |
Providing advanced diagnostics with accuracy, reliability, affordability, and compassionate patient care.

Microscopic study of tissues to diagnose diseases, cancer, and cellular abnormalities for accurate treatment.

Analyzes chromosomes and genetic material to detect inherited disorders, chromosomal abnormalities.
Identifies bacteria, viruses, fungi, and parasites to diagnose infections and guide effective antimicrobial.








